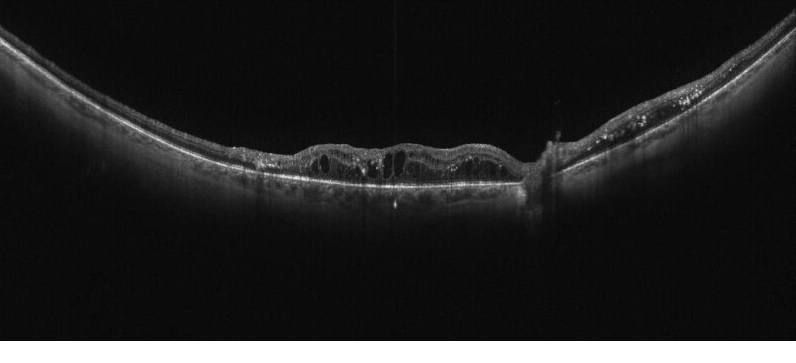
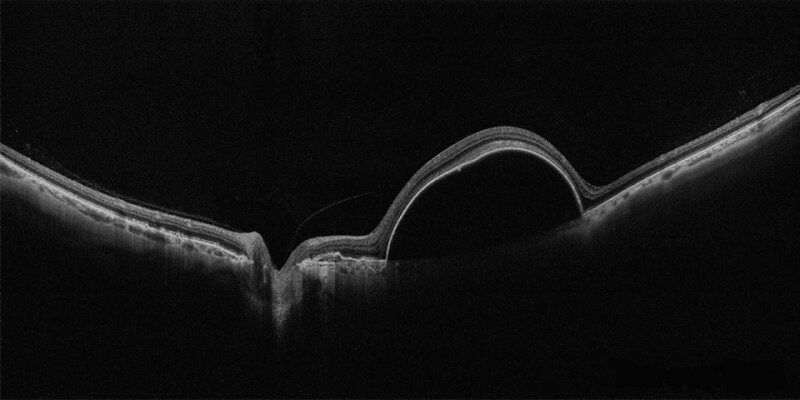

АКЦІЇ! ПЕРЕГЛЯНУТИ ПОВНИЙ ПЕРЕЛІК ДОСТУПНИХ ПРОПОЗИЦІЙ МОЖНА ТУТ
Категорії новин:
Скануйте ширше та глибше з Canon Xephilio OCT-S1
Xephilio OCT-S1 забезпечує прекрасне проникнення крізь щільні структури та створення високоякісних томографічних зображень не тільки ділянки макули та диска зорового нерву але й периферичної сітківки. Серед оптичних когерентних томографів з частотно-модульованим джерелом лише Canon Xephilio OCT-S1 забезпечує ширину зображення у 23 мм з глибиною 5,3 мм. Ви отримуєте більше діагностичної інформації за один скан з неперевершеною якістю зображення навіть при скануванні важких пацієнтів.
З режимів сканування сітківки ОКТ Xephilio OCT-S1 ви можете обрати протоколи сканування зі щільністю сканів:
- 2048 x 512 (Custom 3D),
- 2048 x 2048, 4096 x 4096 (Multi-cross / Cross),
- 2048, 4096 (Radial - 12 напрямків з інтервалом 15 градусів).
Точне вирівнювання на передньому відрізку на Xephilio OCT-S1 виконується за допомогою джойстика, управління підтримано декількома автоматичними функціями. Вбудований скануючий лазерний офтальмоскоп в реальному часі проводить ретинальний трекінг та точне відстеження.
Технологія Canon Deep Learning Intelligent Denoise пропонує нову якість ОКТА зображень на базі одиночних сканів – без необхідності захоплення та усереднення декількох зображень. Революційна технологія Intelligent Denoise дозволяє отримувати зображення високої якості з високим рівнем зниження шумів та покращеним оглядом за кілька секунд.
При скануванні в режимі OCTA є вибір оптимальної щільності зображень від 232x232 пікселів до 928х807 пікселів та форматів зображень квадратної або прямокутної форми від 3 x 3 до 23 х 20 мм. Програмне забезпечення Mosaic дозволить вам створити ультраширокі ОКТА зображення розміром до 31 x 27 мм.
Неймовірні зображення з Xephilio OCT-S1:

Передній відрізок після іридотомії
Діабетична ретинопатія
Серозне відшарування пігментного епітелію

Широкопольне зображення En-Face
- Tags:
- Корисні статті
- Офтальмологія
Останні новини та події
